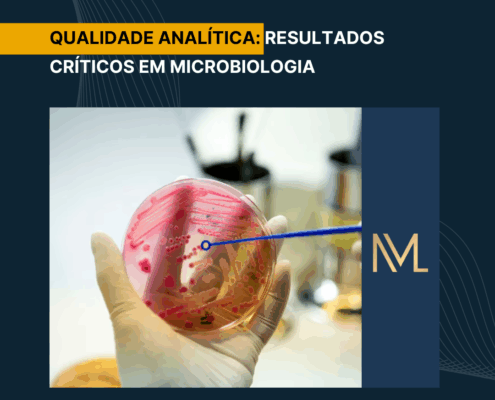

PSA – ANTÍGENO PROSTÁTICO ESPECÍFICO
O câncer de próstata representa uma das neoplasias mais prevalentes entre os homens, configurando-se como a terceira principal causa de mortalidade por câncer, ficando atrás apenas dos tumores de pulmão e colorretal. Nesse contexto, o…

Dosagem de Íons na Urina
A dosagem de íons na urina é um exame laboratorial essencial para a avaliação do equilíbrio eletrolítico e da função renal. Por meio dessa análise, é possível obter dados valiosos sobre a capacidade do organismo em manter a homeostase…

CENTRIFUGAÇÃO: IMPACTO NAS ANÁLISES LABORATORIAIS
Os laboratórios clínicos utilizam amplamente a centrífugação como uma das etapas mais importantes no preparo das amostras. Por meio dessa técnica, os profissionais aplicam uma força centrífuga que acelera a separação dos componentes…

LACTATO DESIDROGENASE: RELEVÂNCIA CLÍNICA
A lactato-desidrogenase é uma enzima da classe das oxidorredutases que catalisa a oxidação reversível do lactato a piruvato, em presença da coenzima NAD+, que atua como doador e aceptor de hidrogênio.
Lactato + NAD+ ↔ Piruvato +…
QUALIDADE ANALÍTICA: Resultados Críticos em Microbiologia
No laboratório clínico, alguns resultados simplesmente não podem esperar. Em especial na microbiologia, eles representam situações em que o intervalo entre o diagnóstico e a conduta médica pode, literalmente, definir o desfecho do paciente.…

Diferenças entre plasma e soro
No contexto das análises clínicas e da medicina laboratorial, compreender a distinção entre plasma e soro é essencial. Apesar de ambos representarem a fração líquida do sangue, suas composições bioquímicas e indicações…

Intoxicação por Cobre
O cobre é um elemento metálico essencial para a manutenção da vida. Apesar de sua necessidade em pequenas quantidades, ele desempenha um papel crucial no funcionamento de diversas metaloenzimas celulares, como a citocromo oxidase, superóxido…

A Regra 1:3s no Controle da Qualidade
No contexto do controle da qualidade laboratorial, a precisão e a exatidão dos resultados analíticos são fatores fundamentais para a confiabilidade dos diagnósticos e, consequentemente, para a segurança do paciente. Para garantir esse…

Controle Interno para Fitas Reativas de Urina
O exame de urina tipo I é um dos mais solicitados na rotina laboratorial. Ele fornece informações valiosas sobre o estado de saúde do paciente, bem como é a primeira pista para diagnósticos de doenças renais e metabólicas. No entanto,…

Inclusão da CPK no Teste do Pezinho
A triagem neonatal, conhecida popularmente como teste do pezinho, é uma ferramenta consolidada para a identificação precoce de diversas doenças genéticas, metabólicas e endócrinas. Recentemente, a inclusão da dosagem da creatina fosfoquinase…
